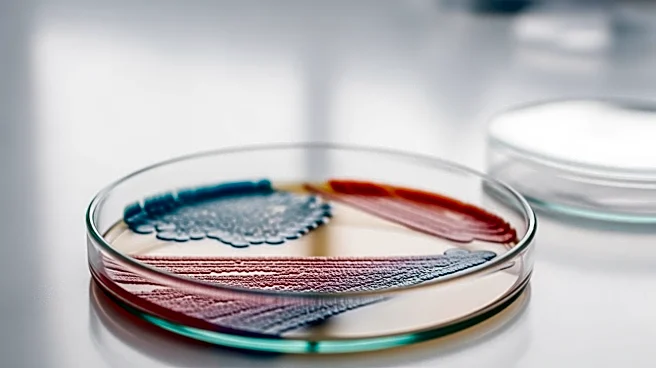
Gut Microbiome Changes Linked to Parkinson's Disease Risk

What's Happening?
Registered dietitian Natalie Rizzo emphasizes the health benefits of consuming yogurt daily, provided certain factors are considered. Yogurt is rich in protein, calcium, and probiotics, making it a nutritious choice for meals or snacks. However, Rizzo advises
selecting yogurts with high protein content and minimal added sugars to maximize health benefits. Greek yogurt and skyr are recommended for their higher protein levels compared to regular yogurt. Rizzo also suggests being mindful of the fat content, recommending low-fat options for those concerned about saturated fat intake. The American Heart Association's guidelines on sugar intake are highlighted, noting that some yogurts can contain significant amounts of added sugars, which should be limited.
Why It's Important?
The advice provided by Rizzo is significant as it addresses common dietary concerns related to sugar and fat intake, which are critical for maintaining heart health and managing weight. Yogurt's role in supporting gut health through probiotics is also emphasized, which can have broader implications for overall health, including immune function and digestion. By choosing the right type of yogurt, consumers can enjoy the nutritional benefits without the drawbacks of added sugars and unhealthy fats. This guidance is particularly relevant in the context of rising health issues such as obesity and heart disease, which are linked to poor dietary choices.